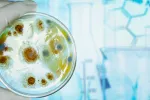

Ingerir menos calorías potencia los músculos y ayuda a envejecer mejor

16/10/2023
Una alimentación equilibrada que aporte todos los nutrientes que necesita nuestro organismo, pero con una menor cantidad de calorías es una de las medidas más eficaces para evitar el exceso de peso y sus consecuencias adversas, como la obesidad y la diabetes, pero también puede ayudar a prevenir o retrasar algunas de las enfermedades asociadas al envejecimiento.
Una nueva investigación ha comprobado, de hecho, que reducir la ingesta total de calorías puede potenciar la fuerza de los músculos, a pesar de que con la edad se pierda masa muscular, y contribuir a un envejecimiento saludable. El estudio ha sido realizado por investigadores de los Institutos Nacionales de Salud (NIH) de Estados Unidos y sus colegas.
En modelos animales ya se había comprobado que disminuir el número de calorías consumidas sin dejar por ello de aportar al cuerpo las vitaminas y minerales esenciales –lo que se conoce como restricción calórica– retrasa la progresión de las enfermedades asociadas con el envejecimiento. El nuevo trabajo se ha publicado en Aging Cell y sugiere que en los seres humanos se pueden aplicar los mismos mecanismos biológicos.
Una ligera reducción de calorías obtuvo buenos resultados
Para llevar a cabo el estudio se analizaron los datos de personas que habían participado en la Evaluación Integral de Efectos a Largo Plazo de Reducción de la Energía (CALERIE), un estudio apoyado por el Instituto Nacional sobre Envejecimiento (NIA) que evaluó si la restricción moderada de calorías proporciona los mismos beneficios para la salud que se habían observado en estudios con animales.
“Dado que la inflamación y el envejecimiento están fuertemente relacionados, la restricción calórica representa un poderoso enfoque para prevenir el estado proinflamatorio que desarrollan muchas personas mayores”
Durante un periodo de dos años el objetivo para los participantes era reducir su ingesta calórica diaria en un 25%, pero el grupo solo pudo alcanzar una reducción del 12% como máximo. Sin embargo, esta ligera disminución de calorías fue suficiente para activar la mayoría de las vías biológicas que son importantes para un envejecimiento saludable.
“Una reducción del 12% en la ingesta de calorías es muy modesta”, ha afirmado el Dr. Luigi Ferrucci, autor correspondiente y director científico de NIA. Y añade que “este tipo de pequeña reducción en la ingesta de calorías es factible y puede constituir una gran diferencia en su salud”.
Los investigadores intentaron comprender los fundamentos moleculares de los beneficios observados en la investigación previa sobre restricción calórica en humanos. Un estudio mostró que los individuos que restringieron su ingesta de calorías perdieron masa muscular y un promedio de 9 kilos durante el primer año y mantuvieron su peso por segundo año. Sin embargo, a pesar de perder masa muscular, los participantes en restricción calórica no perdieron fuerza muscular, lo que indica que la restricción calórica mejoró la cantidad de fuerza generada por cada unidad de masa muscular, llamada fuerza específica muscular.
Para realizar el nuevo estudio, los científicos utilizaron biopsias musculares del muslo de los participantes de CALERIE, que fueron recolectadas cuando los individuos se unieron al estudio, y en seguimientos de un año y dos años. Para averiguar qué genes humanos fueron afectados por la restricción calórica, los científicos aislaron el ARN mensajero (ARNm) –una molécula que contiene el código para las proteínas– a partir de muestras musculares.
Determinaron la secuencia de proteínas de cada ARNm y emplearon esta información para identificar a los genes que originaron ARNm específicos. Otros análisis ayudaron a los investigadores a establecer qué genes estaban regulados durante la restricción calórica, –lo que significa que las células hicieron más ARNm–, y cuáles fueron regulados, lo que significa que las células produjeron menos ARNm.
Los investigadores confirmaron que la restricción de calorías afectó las mismas vías genéticas en humanos que en ratones y primates no humanos. Por ejemplo, una absorción calórica más baja de los genes regulados responsables de la generación de energía y el metabolismo, y los genes inflamatorios regulados que conducen a una menor inflamación. “Dado que la inflamación y el envejecimiento están fuertemente relacionados, la restricción calórica representa un poderoso enfoque para prevenir el estado proinflamatorio que desarrollan muchas personas mayores”, concluye Ferrucci.
Actualizado: 16 de octubre de 2023